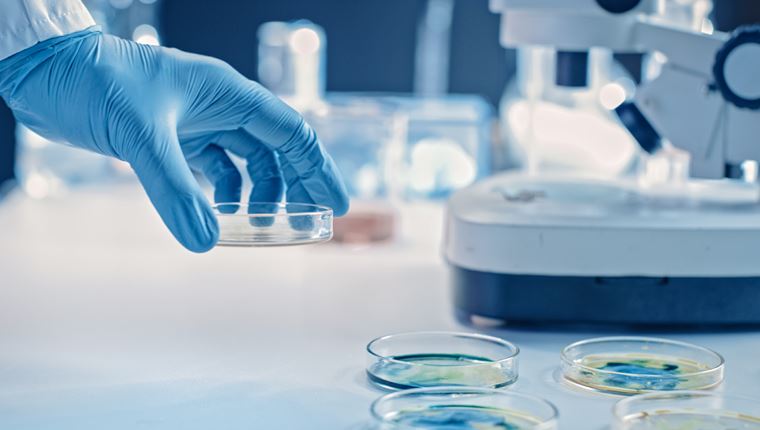
Η ελπιδοφόρα θεραπεία για τον κορονοϊό από την AbCellera

Τι πρέπει και τι δεν πρέπει να κάνεις πριν και μετά το εμβόλιο
Άφθονο νερό, ύπνο και σωστή διατροφή χωρίς πολλά λιπαρά που περιλαμβάνει φρούτα και λαχανικά συνίσταται πριν και μετά τον εμβολιασμό.
Πότε μπορεί να κηρυχθεί το το τέλος της πανδημίας
Η κανονικότητα ποτέ δεν σήμαινε "απόλυτη ασφάλεια". Ένας ασφαλέστερος κόσμος πιθανότατα θα περιλαμβάνει τη συνύπαρξη με τον κορονοϊό.
Το τέλος του lockdown
Αλλαγή σελίδας μετά από 6 μήνες. Τι ισχύει από σήμερα.
Μπορούσε να αποτραπεί η πανδημία;
Μία ανεξάρτητη επιτροπή ειδικών του ΠΟΥ κάνει λόγο για σημαντικά λάθη και έναν χαμένο μήνα στην περίπτωση της Covid-19.
Η χώρα με το παγκόσμιο ρεκόρ εμβολιασμού κατά του κορονοϊού
Το Ναουρού κατάφερε να εμβολιάσει το σύνολο του ενήλικου πληθυσμού της.
Μετά την πανδημία, έρχεται (και) το revenge travel
Η νέα τάση στα ταξίδια, όταν ο κορονοϊός θα έχει νικηθεί.
Η ελπιδοφόρα θεραπεία για τον κορονοϊό από την AbCellera
Το υποψήφιο αντίσωμα για τη θεραπεία του κορονοϊού "1404" ίσως αποδειχθεί εξαιρετικά αποτελεσματικό.
Νεπάλ, η νέα Ινδία
Η εικόνα της εξάπλωσης του κορονοϊού στην ασιατική χώρα είναι άκρως ανησυχητική.
Γραφει Μπαμπης ΔουκαςΗ συμβολή της Ευρωπαϊκής Ένωσης κατά του κορονοϊού παγκοσμίως
Κάνει αρκετά η ΕΕ για να καταπολεμήσει τον κορονοϊό σε παγκόσμιο επίπεδο;
H τραγωδία της Ινδίας αφορά όλο τον πλανήτη
Εμβολιασμοί στον αέρα, μαζικά προσκυνήματα, μέτρα προστασίας που δεν γίνονται σεβαστά, χάος στο σύστημα υγείας και μία νέα μετάλλαξη του ιού.
Γραφει Παναγιωτης ΚουσταςΑνοίγει η εστίαση στις 3 Μαΐου
Σε εξέλιξη η συνεδρίαση των ειδικών.
Η κανονικότητα πλησιάζει, το Netflix χάνει νέους χρήστες
Ήταν το στήριγμά μας στο lockdown, όμως όλα κάποτε τελειώνουν.
ΚορονοΪός: Eκτόξευση ιικού φορτίου στην Αττική κατά 171%:
Αττική, Άγιος Νικόλας και Ρέθυμνο στο στόχαστρο της πανδημίας.